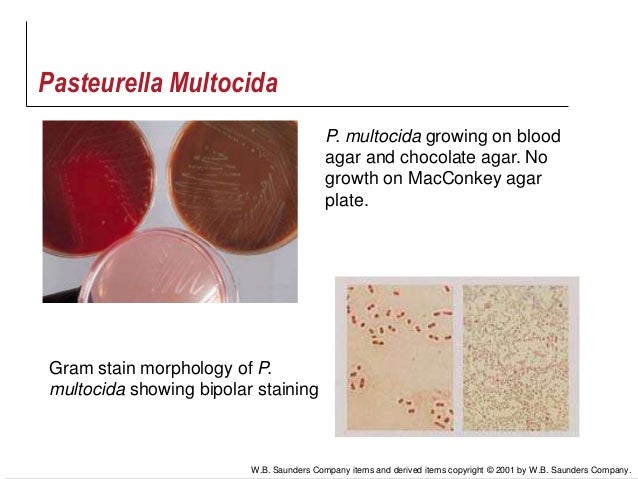

In humans penicillins are first line therapy. Rimler in encyclopedia of immunology second edition 1998.
Pasteurella Multocida Colonies On Blood Agar
Common symptoms of pasteurellosis in humans include swelling cellulitis and bloody drainage at the site of the wound.
P multocida. Uncomplicated diseases in which p. However pairs and short chains can also be seen. Multocida is a small gram negative bacterium.
By infecting humans a wide range of clinical pictures can evolve varying from mild local cellulitis to more severe systemic diseases eg meningitis pneumonia endocarditis and bacteremia. Multocida a gram negative non motile facultative coccobacillus belonging to the pasteurellaceae family is an opportunistic pathogen and common inhabitant of the upper respiratory tract of many animal species and a causative agent of numerous economically important diseases worldwide including atrophic rhinitis ar in swine fowl cholera in. Guo et al 2012.
For patients with penicillin allergies second line agents include. Multocida is the primary etiologic. Pasteurella haemolytica is a species that infects mainly cattle and horses.
How to say multocida in english. Pronunciation of multocida with 1 audio pronunciation 1 translation and more for multocida. Pasteurella multocida is a small gram negative nonmotile nonspore forming coccobacillus with bipolar staining features.
Pasteurella multocida is primarily a veterinary pathogen that produces septicemic or respiratory diseases in both domesticated and wild mammals and birds. Pasteurella multocida is a small gram negative facultatively anaerobic coccobacillus that inhabits the normal microbiota of the respiratory tract of several animals especially cats and dogs. The organism can occur as a commensal in the nasopharyngeal region of apparently healthy animals.
Multocida is the cause of a range of diseases in mammals and birds including fowl cholera in poultry atrophic rhinitis in. The bacteria typically appear as single bacilli on gram stain. In 1878 pasteurella multocida was discovered in birds infected with cholera.
Pasteurella multocida is a small gram negative nonmotile nonspore forming coccobacillus with bipolar staining features. However pairs and short chains can also be seen. It is a non motile coccobacillus and is penicillin sensitive 7.
Pasteurella multocida is a gram negative nonmotile coccobacillus that causes pasteurellosis also known as snuffles the primary respiratory disease affecting domestic rabbits deeb and digiacomo 2000. The bacteria typically appear as single bacilli on gram stain. Strains of the species are currently classified into five serogroups a b d e f based on capsular composition and 16 somatic serovars 116.
Multocida is the most frequent causative agent in human pasteurella infection. Then in 1880 louis pasteur isolated it. Pasteurella multocida is a gram negative nonmotile penicillin sensitive coccobacillus of the family pasteurellaceae.
P multocida often exists as a commensal in the upper respiratory tracts of many livestock poultry and domestic pet species especially cats and dogs. It can cause infections in humans as a result of cat or dog bites and scratches 12.
 Pasteurella Mannheimia And Bibersteinia Flashcards Quizlet
Pasteurella Mannheimia And Bibersteinia Flashcards Quizlet
 Table 1 From Phenotypic Variability Among Strains Of Pasteurella
Table 1 From Phenotypic Variability Among Strains Of Pasteurella
 Microbiological Diagnosis Of Bovine P Multocida And M
Microbiological Diagnosis Of Bovine P Multocida And M
 Pasteurella Multocida Specific Bacteriophage Suppresses P
Pasteurella Multocida Specific Bacteriophage Suppresses P
 Asm On Twitter Components Responsible For Intracellular Activity
Asm On Twitter Components Responsible For Intracellular Activity
 Pasteurella Multocida Mechanisms Of Pathogenicity
Pasteurella Multocida Mechanisms Of Pathogenicity
Haemophilus And Other Fastidious Gram Negative Rods Certified Fixed
Haemophilus And Other Fastidious Gram Negative Rods Certified Fixed
 Pasteurella Multocida Mechanisms Of Pathogenicity
Pasteurella Multocida Mechanisms Of Pathogenicity
 Influence Of Systemic Fluoroquinolone Administration On The
Influence Of Systemic Fluoroquinolone Administration On The
 Bunnyvac Pasteurella Multocida Vaccine For Rabbits
Bunnyvac Pasteurella Multocida Vaccine For Rabbits
 Pasteurella Multocida In Bacteria Zoo Bacteria Cartoons
Pasteurella Multocida In Bacteria Zoo Bacteria Cartoons
 Pasteurella And Similar Organisms Clinical Gate
Pasteurella And Similar Organisms Clinical Gate
 Phylogenetic Analysis Of Pasteurella Multocida Subspecies And
Phylogenetic Analysis Of Pasteurella Multocida Subspecies And
 Pasteurella I Institute Of Microbiology And Epizootics
Pasteurella I Institute Of Microbiology And Epizootics
 Distribution Of Carrier State To P Multocida Between Age Groups
Distribution Of Carrier State To P Multocida Between Age Groups
 Microbiological Diagnosis Of Bovine P Multocida And M
Microbiological Diagnosis Of Bovine P Multocida And M
Plos One Pasteurella Multocida Involved In Respiratory Disease Of
Excellent, if you are looking for picture and video information related to p multocida, you have come to visit the right website. Our website will give you information on p multocida images of the highest quality, search and find the content as well as more innovative and attractive images that suit your taste. p multocida images was selected from one of thousands of image collections from various Search Engine sources, especially Google and Bing, so we recommends this p multocida page for you to see. You can also contribute to supporting this website by sharing images that you like on this blog on your social media accounts such as Facebook, Pinterest, and Instagram or tell your closest friends share your experiences about the ease of access to downloads and information you get on this website .
If you find this site useful to support us by sharing this website's article posts to your favorite social media accounts like Facebook, Instagram and so on or you can also mark this blog page with the title p multocida by using Ctrl + D for devices a laptop with a Windows operating system or Command + D for laptops with an Apple operating system.

Comments
Post a Comment